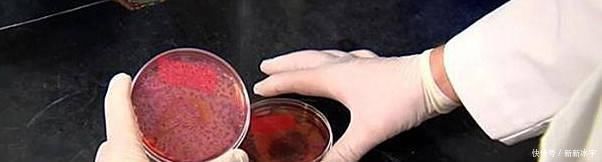
大厨教你粉条不粘锅又好吃的做法,一学就会,比饭店做的还好吃

文章插图
【大厨教你粉条不粘锅又好吃的做法,一学就会,比饭店做的还好吃】【粉丝炒黄豆芽】
材料:粉条1把,黄豆芽,盐,青红椒少许,香油,玉米油,干辣椒,胡椒粉,无添加酱油,大蒜
【做法】1、粉条温水下锅,水开后煮1分钟,七成熟时用漏勺捞出,沥干水分,用筷子挑一挑,使粉条快速降温,然后装进一大盆中,加入适量玉米油拌一拌,目的是防止粘连,然后加入一点胡椒粉、香油适量、无添加酱油适量,拌匀备用
文章插图
2、就煮粉条水烧开,放入黄豆芽煮1分钟,去除豆腥味,煮7成熟捞出控水。
3、青红椒切丝,大蒜拍碎,干辣椒切段。
4、热锅冷油,端起锅滑一下油,放入大蒜、干辣椒大火爆香,然后放入粉条翻炒,炒香炒透粉条放入黄豆芽、青红椒丝一同翻炒。
5、炒1分钟炒熟豆芽,出锅。粉条软糯,黄豆芽清脆,越吃越香!

文章插图
推荐阅读
- 教你自制岩烧乳酪
- 教你做虎皮蛋糕上的虎皮,掌握2个技巧,保证起虎皮,做法很简单
- 不用油不用牛奶,教你做蜂蜜蛋糕,蒸或烤都可以,只需4种食材
- 春天来了教你几道好吃不油腻的家常菜,美味简单下饭,百吃不厌!
- 冬天到了,教你几道暖胃家常菜,营养健康,孩子营养不发愁!
- 春节过后请客吃饭教你几道美味特色的下酒菜,简单易学,味道超赞!
- 家庭版的鱼香肉丝,鲜香可口,在家也能做出大厨的味道
- 想吃点心不用买,教你在家做“驴打滚”,不用烤箱,软糯香甜!
- 特爱吃的几道家常菜,轻松拿下,让你秒变大厨!好吃又下饭营养
- 家常炖老母鸡,不用炖3小时,教你一妙招,40分钟鸡肉软嫩入味
